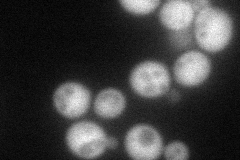
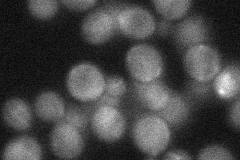
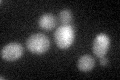

View description
Protein that interacts physically and genetically with Tap42p, which regulates protein phosphatase 2A; component of the TOR (target of rapamycin) signaling pathway
Localization:
Intensity:
Fold change:
Significance:
-
C’ GFP library in SD

below threshold18.15 -
N' NOP1pr-GFP in SD
cytosol90.9375 -
N' TEF2pr-mCherry in SD

missing0 -
N' NATIVEpr-GFP in SD
cytosol33.0474 -
N' TEF2pr-VC and Cyto-VN in SD

#N/A0 -
C’ GFP library in SD+DTT
cytosol19.21.05No -
C’ GFP library in SD+H2O2

cytosol19.591.07No -
C’ GFP library in Starvation Media

cytosol26.761.47No -
C’ GFP library on the background of Pup2-DaMP

below threshold -
C’ GFP library on the background of CCT mutant

below threshold18.53721.02084No
